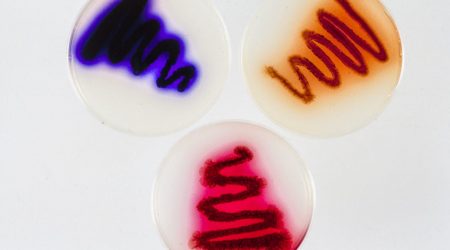

The history of plant science and microbial science at the John Innes Centre
The John Innes Horticultural Institution was founded in 1910 at Merton in South London under the directorship of William Bateson. We moved to Norwich in 1967, becoming the John Innes Centre in 1994. This is our history and the history of plant science and microbial science done here through the years.
 1900
1900
Rediscovery of Mendel's paper
Three independent researchers (Austrian agricultural botanist Erich Tschermak, German botanist Karl Correns, and Dutch botanist Hugo de Vries) published responses to an 1865 paper by Gregor Mendel titled ‘Versuche über Pflanzen-Hybriden’ (Experiments on Plant Hybridisation) which gave the results of eight years of crossing experiments with 22 true-breeding varieties of the garden pea, Pisum sativum L. The ‘principles’ derived from Mendel’s paper have been considered the foundation of modern genetics ever since, and the story of Mendel’s ‘rediscovery’ is one of the most popular and most debated in the history of science.
 1901
1901
Defending Mendel
Mendel’s work was first introduced into England by Cambridge biologist William Bateson in the published version of his address to the Royal Horticultural Society on May 8th, 1900. He also arranged for the publication of the first English translation in the RHS journal in 1901. Its original reception was controversial, leading Bateson to publish a short follow-up book Mendel’s 'Principles of Heredity: A defence' in 1902.
 1904
1904
Death of John Innes
London property developer and philanthropist John Innes (1829-1904) made a new will a week before he died, instructing that the bulk of his fortune should be used to establish a school for horticultural instruction or a local museum and art gallery. The will also mentioned the people and charities closely associated with him in his home borough of Merton, south London. The Innes family contested the will (unsuccessfully) and the John Innes Charity was formed (now the John Innes Foundation).
 1905
1905
Word 'Genetics' coined by William Bateson
In a letter to Cambridge professor Adam Sedgwick, 18 April 1905, William Bateson wrote: ‘If the Quick Fund were used for the foundation of a Professorship relating to Heredity and Variation the best title would, I think, be “The Quick Professorship of the Study of Heredity”. No single word in common use quite gives this meaning, and if it were desirable to coin one, ‘Genetics’ might do’. Bateson first proposed the new word in public at the ‘Third International Conference on Hybridisation and Plant Breeding’ organised by the Royal Horticultural Society in July 1906.
 1910
1910
John Innes Horticultural Institution founded
John Innes’s bequest involved the John Innes Charity in protracted negotiations with the Board of Agriculture, the Board of Education and the Charity Commissioners. In 1909 the parties agreed to establish a new institute which would be an advanced training school for gardeners, a fruit-breeding research station and an institution for ‘horticultural experiment and research with an emphasis on plant genetics. Two acres of John Innes’ estate at Merton Park, became the ‘John Innes Horticultural Institution’, later extended to 6 acres. Professor William Bateson started his appointment as first Director on 1 January 1910 (a position he held until his death in 1926). The John Innes was the first research centre for the study of plant genetics in Britain.
 1919
1919
William Bateson and E R Saunders found the Genetical Society
On 25 June 1919 Professor William Bateson and E R (Rebecca) Saunders convened a meeting in the Linnaean Society’s rooms at Burlington House, London to propose founding a 'Genetical Society'. The proposal was approved unanimously. The first meeting of the Society was held in Cambridge on 12 July 1919; 34 members attended, with John Innes staff forming a high proportion of the membership.
 1926
1926
Death of William Bateson and a new Director
Professor William Bateson, founding figure of English genetics, died after a brief illness on 8 February 1926 at the age of 64. C D Darlington later wrote: ‘The disappearance of his powerful personality left English genetics looking very empty indeed …’ Without Bateson the John Innes Horticultural Institution faced an uncertain future. After an unsuccessful search for a geneticist of Bateson’s calibre to fill the Director’s post, the Council appointed Sir Alfred Daniel Hall, a former Director of Rothamsted Research Station, and a prominent figure in government policy on agricultural and horticultural research. However, he lacked specialist knowledge of genetics, so recruited J B S Haldane to take charge of the genetics experiments.
 1927
1927
Dorothy Cayley discovers the cause of ‘breaking’ in tulips
Dorothy Cayley, John Innes mycologist, showed that ‘breaking’ in tulips is caused by a transmissible virus. ‘Breaking’ describes colour variegation of the petals into splashes, stripes or lines distributed on a white or yellow background. This pretty effect was nevertheless a commercial disadvantage; many tulip growers wanted to ‘rectify’ their tulips to get ‘true’ colours. Cayley’s work showed that colour ‘breaking’ was due to ‘virus or enzyme infection’, probably spread by aphid attack. Her experiments suggested the degree of breaking was proportional to the amount of infected tissue introduced and was published in the 'Annals of Applied Biology' in November 1928.
 1931
1931
Rose Scott-Moncrieff pioneers ‘biochemical genetics’
Dr Rose Scott-Moncrieff was encouraged by JBS Haldane to form one of the very first teams working on ‘biochemical genetics’. She linked the chemical knowledge of Professor Sir Robert and Lady Gertrude Robinson at Oxford, with her own analytical expertise, and work by staff at the John Innes on genetic variation in flower colour. Scott-Moncrieff went on to publish a series of ground-breaking papers in the 1930s identifying some of the enzymes in the biochemical pathways of pigment biosynthesis in flowering plants and the genetic basis for these biochemical activities. Her work was recognised as fundamental in establishing the emerging field of biochemical genetics.
 1933
1933
First commercial ‘John Innes’ fruit varieties released
Soon after the John Innes was established research on the genetics of fruit began, including raspberries, strawberries, apples, pears, plums and cherries. Many of the early crossing experiments were exploratory to study inheritance and were not aimed at producing new varieties. The John Innes launched its first commercial fruit varieties with a trio of blackberries: ‘John Innes’ (1933); ‘Merton Early’ (1936) and ‘Merton Thornless’ (1941). Overall the John Innes released 50 new fruit varieties (most early varieties included the prefix ‘Merton’), and many received the RHS Award of Merit. Additionally, 28 new flower-varieties and 15 vegetable varieties were produced. Our fruit breeding research ended in 1982.
 1937
1937
J B S Haldane publishes the first evidence of sex linkage in humans
J B S Haldane was appointed ‘Head of Genetical Work’ after Professor William Bateson’s death. Haldane’s introduction to the institute’s long-running studies of the ornamental plant Primula sinensis provided him with the material for his most important contribution to linkage theory, in collaboration with Dorothea de Winton. Furthermore, Haldane’s contact with John Innes cytologists led to publications on the cytological basis of genetic interference, and his search for possible partial sex linkage in humans. In 1937 Haldane published the first evidence of sex linkage in humans (haemophilia and colour blindness) with UCL colleague Julia Bell.
 1938
1938
John Innes Compost formula published
Garden Curator William Lawrence and his assistant John Newell undertook a long series of trials to find an improved growing medium for the institute’s experimental plants, prompted by heavy losses of Primula sinensis seedlings in the 1933-34 season. After hundreds of trials, they perfected methods of soil sterilisation, established optimum amounts of N, P and K fertilisers required, and arrived at two standardised ‘John Innes’ composts, publishing, but not patenting them in 1938. As part of the war effort John Innes staff then published a series of leaflets and gave radio broadcasts to publicise their new composts and other improved methods for raising garden crops.
 1939
1939
Cyril Darlington elucidates how chromosomes pair and recombine during the formation of gametes
Cyril Darlington (John Innes Director 1939-1953) elucidated how chromosomes pair and recombine during the formation of gametes (meiosis). His 1932 book 'Recent Advances in Cytology', which presented his observations and hypotheses for the first time, created enormous controversy but was widely read and discussed. He enlarged on his views in his 'Evolution of genetic systems' (1939), explaining how chromosomes recombine to establish the link between genetics and heredity. His research on the pairing and segregation of chromosomes, the process of crossing-over, and the timing relationships of meiosis and mitosis, established him as a great influence on cytological thought.
 1948
1948
Pioneering theory of intrasexual selection: ‘Bateman’s Principles’
Dr Angus Bateman published observations on the mating behaviour of fruit flies in the journal Heredity. From his results he formulated what later became known as ‘Bateman’s principles’ or the theory that intrasexual selection is normally more intense in males because they have higher variance in mating success (number of mates); and higher individual variation in reproductive success (number of offspring produced) than females. He reasoned that females almost always invest more energy into producing offspring than males, so that in most species females are a limiting resource over which the other sex will compete. He also concluded, with Darwin, that promiscuity is more advantageous to the male than the female; hence males have evolved an ‘undiscriminating eagerness’ to mate and females a ‘discriminating passivity’- a fundamental sex difference that Bateman suggested applied even to humans. ‘Bateman’s principles’ became one of the grounding paradigms of behavioural biology, used to explain sex-specific selection, sex roles and sexual dimorphism, though later research has demonstrated many exceptions and counter-examples.
 1949
1949
Kenneth Mather coins the term ‘polygene’ and developed a theory of polygenic inheritance
Dr Kenneth Mather coined the term ‘polygene’ to describe a gene whose individual effect on an organism is too small to be observed in the phenotype, but which can act together with other genes to produce observable variations. Polygenic inheritance occurs when one characteristic (for example, height or weight) is controlled by two or more genes. Large numbers of genes may be small in their effect but interact with each other and with the environment to cause observable variation in the organism. His approach combined biometry and genetics into statistical tools for the study of evolution, and for plant and animal breeding. In 1949 he published his first book 'Biometrical Genetics'. Its publication marked Mather’s rise to prominence as one of the most distinguished geneticists of his time and his role as founder of post-war developments in the field.
 1950
1950
The John Innes Horticultural Institution moves to Bayfordbury
Over two years the John Innes Horticultural Institution moved from Merton, to Bayfordbury in Hertfordshire. The 372-acre Bayfordbury estate, near Hertford, was purchased by the John Innes Charity in 1945. Over the next few years construction work converted the Georgian mansion, which had been a Dr Barnardo’s Home, into laboratory space and offices and built 14 new cottages within nearby Broadgreen Wood to accommodate John Innes staff. All the additional facilities needed for a research institute were also built, including glasshouses and roads, with the Ministry of Agriculture contributing to the capital costs of the move. The increased land availability enabled experimentation with glasshouse design and furthered the fruit-breeding and horticultural research programmes. The new John Innes Horticultural Institution was declared open by Lord Cranborne in June 1950.
 1951
1951
MM series of apple root-stocks launched
In the autumn of 1951 a series of woolly aphid-resistant apple root-stocks, raised jointly by John Innes and East Malling Research Station, Kent, were sent to research stations all over the Commonwealth and the United States. The root-stocks, the result of 30 years’ experimental breeding, were named the Malling-Merton series and one is still a standard root-stock for both garden and commercially-grown apples. This series (MM101-114), which also carries genes for powdery mildew resistance, was produced by crossing Malling and Merton root-stocks with Northern Spy.
 1954
1954
Dan Lewis elucidates self-incompatibility mechanisms in plants
Flowering plants have evolved mechanisms to avoid self–fertilisation and promote out-breeding. Dr Dan Lewis elucidated the most common of these mechanisms - self–incompatibility. Self-incompatibility is a genetically controlled pollen–pistil recognition system that provides a barrier to fertilisation by self and self–related pollen in hermaphrodite flowering plants. Lewis’s work on self-incompatibility in the evening primrose, Oenothera organensis, broke new ground and enabled him to predict a molecular recognition between different proteins produced in the pollen and style; these proteins were encoded by tightly linked genes at a complex self-incompatibility (S) locus. Modern molecular techniques have since confirmed his predictions and revealed the actual nature of the proteins and their interactions. Lewis' outstanding review of self-incompatibility mechanisms in 1954 became a citation classic and brought him widespread recognition.
 1957
1957
Advances in the study of anthocyanin plant pigments
Biochemist Dr Jeffrey Harborne developed new methods allowing the separation and structural identification of anthocyanins. He devised suitable solvents for separating pigments with different glycosylation patterns and in a series of articles developed analytical methods combining spectral and chromatographic techniques. For the first time it became possible to identify plant anthocyanins and their sugar components on a micro-scale. This work formed the basis of a career in phytochemistry that has had considerable influence on current research on the genetics and regulation of anthocyanin biosynthesis, and on our understanding of the systematics of flower colour.
 1964
1964
Birth of Holliday Junction
Geneticist Dr Robin Holliday, working on DNA damage and genetic recombination in Ustilago maydis (corn smut) and the yeast Saccharomyces cerevisiae, published a model of DNA-strand exchange to try and explain the major features of crossing-over, gene conversion, and post-meiotic segregation that had been documented in several fungi. His simple model incorporated the cross-stranded (or cruciform) DNA structure that later became known as the ‘Holliday Junction’ (a mobile junction between four strands of DNA). These junctions were later found to occur from prokaryotes to mammals and are central intermediates in the process of homologous recombination. Holliday’s junction became a cornerstone of recombination models once geneticists began to be persuaded that this recombination intermediate might be real.
 1967
1967
The John Innes Institute moves to Norwich
The John Innes moved from Bayfordbury, Hertfordshire to Norwich to form an association with the University of East Anglia. The Agricultural Research Council Virus Research Unit (VRU) at Cambridge (Directed by Dr Roy Markham FRS) was also re-located to Norwich and integrated as a new Department of Virus Studies. Markham was appointed Director of the John Innes Institute and John Innes Professor of Cell Biology. Initially most of the Institute occupied temporary buildings, but Markham’s group was temporarily housed in the new permanent buildings of the neighbouring ARC Food Research Institute.
 1968
1968
Streptomyces genetics programme launched
Research into Streptomyces genetics began when David Hopwood was appointed as Head of Genetics and John Innes Professor of Genetics at the University of East Anglia. Hopwood had developed the basic genetics of S. coelicolor A3 (2) at the University of Glasgow, devising a novel method of linkage analysis, a procedure that later proved useful for genetic studies of other microbes. When Hopwood founded the Streptomyces group in Norwich he had just established a detailed circular linkage map of more than 100 S. coelicolor genes (1967), pioneering work that confirmed S. coelicolor A3 (2) as the model system for the genus. In 1970 Hopwood’s group provided evidence for plasmid-determined mating in S. coelicolor; a key development enabling an efficient natural mating system for genetic analysis.
 1975
1975
First use of protoplasts in plant virology
John Innes scientists with collaborators delivered the first infection of protoplasts (cells with their outer wall removed) using a plant virus, a technique widely used later for getting foreign DNA into plant cells. This new approach to understanding virus replication was the fruit of collaboration between visiting scientist Dr F. Motoyoshi (Japan), John Innes virologists, and the Ultrastructural studies Department.
 1978
1978
First registered ‘leafless’ and ‘semi-leafless’ peas launched
A team in Applied Genetics at John Innes, assisted by the Processors and Growers Research Organisation near Peterborough, developed new ‘leafless’ and ‘semi-leafless’ pea plant models. These plants, in which leaves are replaced by tendrils, especially the semi-leafless form, proved to have advantages for growers, including improved standing ability, machine-harvesting, water-efficiency and yield. In many countries, as the result of extensive breeding, they have come to represent the majority of new varieties being registered and grown. In the UK semi-leafless peas account for 100% of UK dried pea varieties.
 1979
1979
Tools for strain improvement in antibiotics and genetic engineering
In 1977-78 the John Innes Institute and the pharmaceutical firm Eli Lilly (Indianapolis, USA) independently developed genetic recombination through protoplast fusion in Streptomyces. This discovery opened the way to using protoplast fusion as a very efficient means of combining mutations from different selection lines in antibiotic strain improvement and was widely used in pharmaceutical companies. In 1979 Professor Hopwood’s group introduced plasmid DNA into Streptomyces by protoplast transformation; a crucial step in genetic engineering of Streptomyces.
 1983
1983
First edition of The Molecular Biology of the Cell
The first edition of The Molecular Biology of the Cell was published. Co-authored by John Innes scientist Dr Keith Roberts, the book became the leading cell biology textbook, lauded as ‘the most influential cell biology textbook of its time’ (5th edition, 2008). Pictured is the editorial team on the eve of completing the 3rd edition; the book is now in its 6th edition.
 1984
1984
Discovery of gene products behind aphid virus transmission
Dr Peter Markham and colleagues at John Innes discovered a viral gene product (‘aphid transmission factor’) that enabled aphids to acquire the virus particle from infected tissues for transmission to uninfected plants. This led to the general recognition that viral gene products allow virus transmission between plants by aphids.
1985
1985
First hybrid antibiotic by genetic engineering
Francisco (Paco) Malpartida, a Spanish post-doc working in the John Innes Streptomyces group, isolated the complete set of genes required to make a Streptomyces antibiotic. The genes were then expressed in another (heterologous) Streptomyces host. Then, in a collaboration with Japanese and American groups, the John Innes team produced the first model “hybrid” antibiotics by genetic engineering. Their research had a major impact and led in the next decade to the technique of combinatorial biosynthesis of “unnatural natural products” to make novel pharmaceuticals. With its success in developing cloning methods, our Streptomyces group actively embraced a training role, offering practical courses based around its influential 'Genetic Manipulation of Streptomyces: a laboratory manual'. The courses attracted academic and industrial scientists working on natural product pharmaceuticals to Norwich. This and later training initiatives, including the updated manual 'Practical Streptomyces Genetics', has taken our Streptomyces research global.
 1986
1986
Advances in the genetics of flower colour
Two landmark papers by Dr Cathie Martin and Dr Enrico Coen in the EMBO Journal and in Cell respectively, advanced our understanding of the genetic interactions that underlie flower colour patterns in Antirrhinum (snapdragons). By correlating changes in the level and pattern of colour expression with different transposon-induced mutations, Martin and Coen revealed the function of different promoter sequences. Their work was among the first to exploit novel transposon-tagging techniques and resulted from a fruitful collaboration with the Max Planck Institute for Plant Breeding Research (MPIZ) in Cologne. The excitement generated by transposon work in both labs has been credited with originating today’s Antirrhinum research community and reviving Antirrhinum as a model system for understanding plant genetics.
 1990
1990
The Cambridge Laboratory moves to Norwich
In March 1990 the ‘Cambridge Laboratory’ joined the John Innes Institute and the Sainsbury Laboratory on the Colney site in Norwich. This represented the non-privatised arm of the former Plant Breeding Institute, Cambridge, which had been divided up and sold to Unilever in 1987. Their new three-storey building opened with 120 permanent staff, plus visiting scientists, postdoctoral fellows and research students. Special glasshouses, and many other facilities, including a large seed store to hold the Plant Breeding Institute’s nationally important collection of seeds, were also built to replicate the facilities left in Cambridge. Crop science was organised into three new departments: ‘Cereals Research’, ‘Brassica and Oil Seeds Research’, and ‘Molecular Genetics’. This broadened the research base at Norwich to cover the major arable crops, with basic and strategic research using model plants to study genes that regulate key crop traits.
 1991
1991
Influential ABC genetic model for how flowers are formed
Together with Elliot Meyerowitz (USA), Dr Enrico Coen published a key paper describing the influential ABC genetic model for how flowers are formed. Coen’s work on flower development originated in the early 1980s when he began to study the collection of snapdragon (Antirrhinum majus) specimens with mutant flower morphologies assembled at the John Innes Institute over more than three decades. Coen developed a simple model to explain how flower shape develops in snapdragons, and in collaboration with Arabidopsis researchers in the USA, played a key role in popularising the ‘ABC’ model of flower development, which is still widely used as a framework for understanding floral development today.
 1994
1994
Creation of the John Innes Centre
In April 1994 the John Innes Centre was created from the merger of the John Innes Institute, the Cambridge Laboratory, and the Nitrogen Fixation Laboratory, fulfilling the Agriculture and Food Research Council’s policy of creating larger interdisciplinary centres. As part of the arrangements for the merger, the Trustees of the John Innes Foundation gifted the assets of the John Innes Institute to the John Innes Centre and leased the Norwich site to us for 50 years at an annual rental of one tree. With the integration of the three institutes, we secured state-of-the-art research facilities for furthering the understanding and exploitation of plants and microbes.
 1995
1995
Synteny concept published
Dr Graham Moore published his synteny concept in a landmark paper. Using genetic mapping data for rice (from Japan), maize and sorghum (USA), sugar-cane (France), and rye, wheat and millets, Moore and colleagues including Mike Gale showed that the order of genes in regions of the wheat genome is the same as in certain regions of rice and other cereal genomes. As a result, researchers can use rice, which has a much smaller genome than wheat, to find the same genes in wheat, and make predictions from one cereal crop to another. Moore’s concept enabled a step-change in breeding strategies and has been at the heart of wheat breeding and cereal genetics research around the world.
 1999
1999
First plant genome sequenced
An international research group of over 200 scientists, from 35 laboratories, published the complete DNA sequence for chromosomes 2 and 4 of the tiny weed Arabidopsis thaliana (thale cress), two of this plant’s five chromosomes. Professor Mike Bevan oversaw the co-ordination of chromosome 4 sequencing, a major achievement. Arabidopsis thaliana becomes the model plant for crop genetic studies.
 1999
1999
Green Revolution gene identified
Dr Nick Harberd’s team identified and isolated the Rht-1 gene in wheat, based on their work on the model plant Arabidopsis thaliana. This ‘reduced height’ gene was central to the success of the new wheat varieties that were introduced during the ‘Green Revolution’ in the 1960s (shorter plants put more of their energy into grain production, increasing yields). The discovery of Rht-1 gave breeders a perfect genetic marker for the trait, allowing fine control over the height of wheat plants in breeding programmes. Harberd went on to elucidate the molecular mechanisms through which plant hormones control growth in response to environmental change.
 2000
2000
Landmark research on antimicrobial compounds in oats
Professor Anne Osbourn’s lab defined a large multi-gene cluster for the biosynthesis of antimicrobial triterpenes (avenacins) that protects oats against soil-borne pathogens such as take-all. Osbourn’s lab later cloned and characterised all the genes and enzymes of the pathway. Understanding how oats produce these antimicrobial compounds in their roots has the potential to help protect wheat and other cereal crops from serious diseases in the future. The avenacin work was the outcome of the lab’s discovery that genes for the synthesis of different kinds of natural products are organised in biosynthetic gene clusters in plant genomes. This discovery continues to create opportunities to harness the chemical diversity of the plant kingdom to generate new drugs and other high-value compounds.
 2002
2002
Streptomyces genome sequenced
Streptomyces scientists at the John Innes Centre oversaw the genome sequencing of Streptomyces coelicolor A3 (2) by the Sanger Centre in Cambridge, and the subsequent development of a range of genomic tools by UK consortia. The sequence demonstrated for the first time that Streptomyces genomes are very large and teem with unsuspected gene clusters for potentially interesting metabolites, a discovery made amenable to exploitation by the tools developed here at the John Innes Centre
 2004
2004
Outstanding contributions to the study of developmental timing in plants
Professor Caroline Dean was elected FRS and awarded an OBE for her outstanding contributions to the study of developmental timing in plants. Her work on vernalization – the period of cold some plants need to flower - revealed the mechanism by which plants remember they have experienced winter and demonstrated novel RNA processing mechanisms controlling flowering. Her discoveries have broad significance in the fields of epigenetics, post-transcriptional regulation and molecular evolution. Her contributions to developing Arabidopsis as a model have included establishing resources for genetic mapping and insertional mutagenesis and providing physical maps that underpinned the sequencing of the genome. Dean went on to be elected a member of USA’s National Academy of Sciences in 2008 and was made a Dame (DBE) in 2016 for services to plant science research and women in science.
 2005
2005
The Science, Art and Writing (SAW) Trust founded
Professor Anne Osbourn founded the Science, Art and Writing (SAW) Trust, a charity that promotes cross-disciplinary education. The SAW initiative draws on scientific themes, supported by visually striking scientific images, as the starting point for scientific experimentation, art and creative writing. This union of science, art and writing around a central scientific focus represents a powerful way of bringing science into everyday lives and learning. Since its inception thousands of children in the UK, the United States and China have taken part in SAW projects.
 2006
2006
Gene complex that controls how chromosomes pair in wheat sequenced (Ph1)
Dr Graham Moore’s group sequenced a gene complex that controls how chromosomes pair in wheat (Ph1), solving a 50-year puzzle. Understanding chromosome pairing within wheat enables breeders to incorporate genes from wild relatives into the wheat genome to provide beneficial traits for yield and resilience (for example, drought tolerance and disease resistance). Moore began working on the problem in 1987, and during the 1990s, together with colleagues in Cambridge and France, developed genetic resources in wheat, rice and Brachypodium (a grass used as a model plant) to help solve it. Moore’s work in the 2000s was advanced by a collaboration with Professor Peter Shaw who developed novel 3-D cell biological approaches.
 2008
2008
Genetically modified tomatoes developed that could benefit human health
Professor Cathie Martin, Dr Eugenio Butelli and colleagues made a significant breakthrough when they expressed genes from snapdragon (Antirrhinum) in tomatoes to grow purple tomatoes with enhanced levels of anthocyanins. Anthocyanins (a class of pigments produced by higher plants) offer protection against certain cancers, cardiovascular disease and age-related degenerative diseases. There is evidence that anthocyanins also have anti-inflammatory activity, promote visual acuity and hinder obesity and diabetes. Martin’s group’s research was one of the first examples of plant metabolic engineering to offer the potential to promote human health through diet.
 2010
2010
Survey revealed Norwich institutes’ highly cited researchers
The John Innes Centre and The Sainsbury Laboratory were ranked number one for academic citations in the world in the field of plant and animal science, based on an independent survey by Thomson Reuters from its Essential Science Indicators of scientific literature January 1999 - June 2009, published in Times Higher Education.
 2012
2012
Dr Frank Sainsbury and Professor George Lomonossoff awarded BBSRC’s ‘Innovator of the Year’
Frank Sainsbury and George Lomonossoff were awarded BBSRC’s Innovator of the Year award for work on the protein production system Hypertrans®. First published in Plant Physiology in 2008, the technology was the outcome of long-term research to develop technology that turns plants into bio-reactors to make vaccines without producing infectious viral particles. In 2009 the Hypertrans® expression system was used to develop flu H1 virus-like particles in only 14 days. The BBSRC Award in 2012 recognised the system’s potential to rapidly produce new medicines, and it has since been used (in 2017) to produce a synthetic Polio vaccine and winter flu vaccine. In 2017 Leaf Systems International Ltd, was launched, a collaborative spin-out company between the John Innes Centre, BBSRC and Plant Biosciences Ltd that uses Hypertrans® technology to rapidly produce new products within plant tissue.
 2014
2014
Chinese Academy of Sciences - JIC Centre of Excellence launched
The joint Chinese Academy of Sciences (CAS) – JIC Centre of Excellence in Plant and Microbial Science was launched. The new £12m Centre, which spans the two countries, enhances research to support the agricultural technology and microbial genetics agendas of both countries. Funding for the new Centre of Excellence was provided by BBSRC and the John Innes Centre in the UK and by the two CAS institutes in the partnership: the Shanghai Institute of Plant Physiology and Ecology and the Institute of Genetics and Developmental Biology in Beijing.
 2015
2015
High protein ‘super-pea’ developed
A group led by Professor Claire Domoney used non-GM methods to develop a new high-protein pea, which doesn’t have the inhibitors that peas normally contain that stop proteins being absorbed fully when eaten by humans, poultry or livestock. The pea has the potential to cut costs for farmers because livestock need to eat fewer of the new peas to obtain the same amount of protein as standard peas and was developed as a sustainable protein source that can be grown in Europe and could reduce soya imports. The ‘super pea’ research was part of a wider programme to understand the biology and genetics underpinning important pea traits. In 2015 Domoney was awarded the prestigious Royal Agricultural Society Research Medal for work of outstanding merit which promises benefit to agriculture.
 2015
2015
Youth STEMM Awards launched
Initially launched as a pilot with all-female participants, the Youth STEMM Award (YSA) are a Science, Technology, Engineering, Maths and Medicine (STEMM) achievement based award for young people. The Awards were opened up to all genders in 2016 and continue to provides a focused and engaging framework for students aged 13-19 to further their passion, knowledge and skills as they work towards Bronze, Silver or Gold level Awards.
 2017
2017
First independent institute to receive Athena SWAN Gold Award
We become the first independent UK Institute to achieve the Athena SWAN Gold Award; an achievement that reflects an ongoing dedication to becoming a workplace where everyone is treated with fairness, dignity and respect. The award demonstrates the progress we have made on their inclusivity and diversity journey. We recognises that there is still much to do and is looking to understand how to tackle discrimination holistically, knowing that focusing on individual protected characteristics can compound equality issues. Future approaches and initiatives will take into account that individuals have complex, multi-layered identities
 2017
2017
Founding signatory of the Technician Commitment
In May we became a founding signatory of the Technician Commitment, which aims to ensure visibility, recognition, career development and sustainability for technicians working in higher education and research. This followed on from our establishment of the Research and Support Staff Voice (RSSV) Committee that represents all our research and support staff, who play a key role in our scientific output but don't have representation elsewhere
 2018
2018
Complete sequence of wheat genome published
A complete sequence of the wheat genome was published in a paper authored by more than 200 scientists from 73 research institutions in 20 countries – including the John Innes Centre. Sequencing the genome was a huge challenge for scientists. Wheat has a large and complex genome with 16 billion base pairs – the building blocks of DNA – which is more than five times larger than the human genome. The 2018 paper details the sequence of 21 chromosomes, the precise location of 107,891 genes and more than four million molecular markers. In future we can identify genes controlling traits of interest more rapidly and help accelerate the breeding of crops that are higher-yielding, more nutritious, or more resistant to drought, floods and diseases
 2019
2019
Dorothea de Winton Field Station opened
Our purpose-built field experimentation station, the Dorothea de Winton building is officially opened. The facility enables co-location of our large field trials with state-of-the-art laboratories, seed and crop processing facilities and a specialist seed storage unit and is named after Dorothea de Winton; a geneticist who worked for the John Innes Centre from 1920-41.
